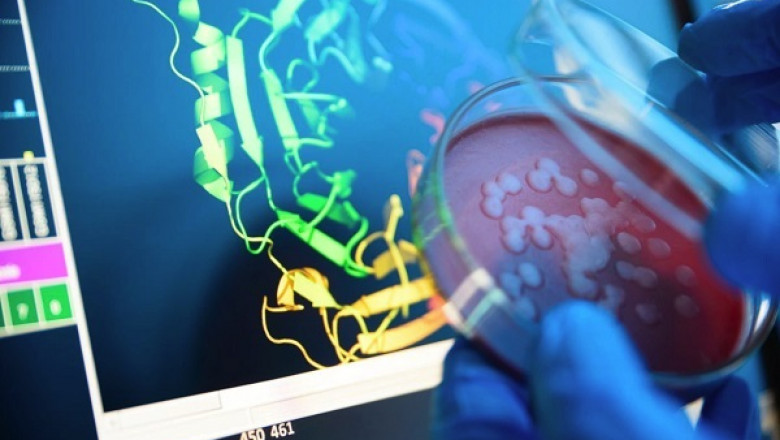

views
Market Snapshot: -
The Global Protein Detection and Quantification market size is estimated to reach $3.3 million by 2026 growing at a CAGR of 5.1% over the forecast period of 2021-2026.
The Protein Detection and Quantification Market research report is proficient and top to bottom research by specialists on the industry's current state in 2022. This statistical surveying report gives the most up-to-date Protein Detection and Quantification Market industry information and industry future patterns, enabling you to distinguish the items and end clients driving income development and benefit. It centres around the real drivers and restrictions for the key players and presents challenge status with development prospects. Additionally, the report displays potential opportunities in the Protein Detection and Quantification Market, and also it features the effect of the different elements bringing about preventing or boosting the market analysis.
Get Sample PDF Copy: https://www.researchinformatic.com/sample-request/229
Overview of the market:
The report presents the market overview with the cost, dispatch, application, use volume, and arrangement. In addition, the Protein Detection and Quantification Market research report offers significant bits of information into the business focus from the early stage, including some steady techniques chalked out by perceptible market pioneers to develop a strong foothold and development in the business. Moreover, the essential areas of the Protein Detection and Quantification Market are also assessed based on their performance.
Competitive Rivalry:
The Protein Detection and Quantification Market report includes a full assessment of the competitive landscape, containing information about the major key players, their strategies for success in the market, and their economic growth.
Check available discounts on this report: https://www.researchinformatic.com/discount/229
Some of the key players are:
- Merck & Co.
- Inc.
- Danaher
- RayBiotech
- Inc.
- Innovate
- Shimadzu Corporation
- PerkinElmer Inc
- Bio-Rad Laboratories
- Inc.
- Thermo Fisher Scientific
- GE Healthcare
- SCIEX among others.
Segmentation Analysis of the market
The Protein Detection and Quantification Market is segmented based on the product, type, end-users, and application. Segmentation is considered the most vital part of the report, which helps the reader understand the market in a précised way.
Do You Have Any Query or Specific Requirement? Ask Our Industry Expert:
https://www.researchinformatic.com/inquiry-229
The report “Global Protein Detection and Quantification Market”, by Research Informatic covers an in-depth detailed analysis for the following segment which are covered under scope.
By Technology
- Colorimetric Assays
- Immunological Methods
- ELISA, Chromatography
- Mass Spectrometry
By Product
- Kits & Reagents
- Consumables
- Instruments
- Services
- Others
By Application
- Drug Discovery & Development
- Clinical Diagnosis
- Others
By End Users
- Biotechnology and Pharmaceutical Companies
- Contract Research Organization
- Academic Research Institutes
Geography
- North America
- Europe
- APAC
- ROW
Get Your Customised Research Report: https://www.researchinformatic.com/request-customization-286
Reasons to buy report.
- The report offers a depth analysis of the Protein Detection and Quantification Market by providing the definition, application, and classifications.
- The SWOT analysis and strategies of each vendor in the market are provided in the report.
- It offers comprehensive insights into current Protein Detection and Quantification Market industry trends, trend forecasts, and growth drivers.
- The report provides a detailed overview of the vendor landscape, competitive analysis, and key market strategies to gain a competitive landscape.
Conclusion:
The Protein Detection and Quantification Market report provides market estimates. It delivers point-by-point subjective information and insight, historical data, and verified market size opinions. The assessments presented in the report were derived through support inquiry about procedures and induction. The Protein Detection and Quantification Market report, as a result, gives us a lot of research and data for every sector of the market.
Browse In-depth Research Informatic Report (250 Pages) on Protein Detection and Quantification Market @ https://researchinformatic.com/reports/protein-detection-and-quantification-market-229
Check out more studies related Reports, published by Research Informatic:
- Animal Ultrasound Market Size, Share, Growth | Industry Forecast Report, 2026
- Health Data Archiving Market Size, Share, Growth | Industry Forecast Report, 2026
- DNA Origami Market Size, Share, Growth | Industry Forecast Report, 2026
About Us:
Research Informatic is a bulging market research and consultancy company based in Nevada, United States, with a report distribution centre in India. We are committed to assisting our clients in making critical business decisions by fulfilling their niche market research needs. Our clients are spread across more than 130 countries and in all business domains. Our service offerings include syndicated research, tailored research, consumer surveys, and consulting. We concentrate on making investment decisions based on a variety of criteria such as growth size, benefits strategies, technical advances, and changing consumer inclinations, to name a few.
Our syndicated and custom research reports assist our customers in growing their businesses across a broad range of industries. In the fields of healthcare, chemicals and materials, ICT, Automation, Semiconductors & Electronics, Consumer goods, Energy, Food & Beverages, and Packaging, we include research studies in the form of syndicate reports, custom reports, market surveys, and consultancy projects.
Contact Us:
George Miller
1887 Whitney Mesa
Dr. Henderson, NV 89014
+1 775 237 4147
https://researchinformatic.com
Web: https://www.researchinformatic.com/categories/life-science
Follow us on LinkedIn: https://www.linkedin.com/company/research-informatic/mycompany/
Related News Article: -
- Valkyrie’s Amphibious, Jet-Powered High-Speed eVTOL is Backed By US Air Force - NUNewsIndustry
- CNN President Jeff Zucker Resigns - NUNewsIndustry
- European Union and United States Urge Serbia and Kosovo to Negotiate - NUNewsIndustry